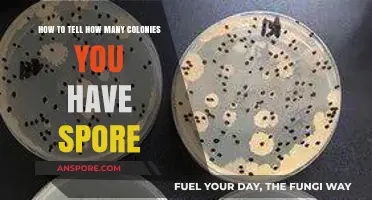
Counting Spore Colonies: Accurate Methods to Determine Your Colony Count

Terraforming a planet in *Spore* is a captivating and strategic process that allows players to transform barren, uninhabitable worlds into thriving ecosystems capable of supporting life. By harnessing the game’s tools and resources, players can alter a planet’s atmosphere, temperature, and vegetation to meet the needs of their species. This involves balancing environmental factors, such as introducing plant life to generate oxygen, managing heat levels, and ensuring the planet’s habitability for both indigenous and introduced creatures. Mastering terraforming not only enhances the player’s ability to colonize new worlds but also deepens their understanding of ecological interdependence and planetary science within the game’s creative sandbox.
| Characteristics | Values |
|---|---|
| Terraforming Tool | Terraforming Tool (purchased from the Space Stage Spaceport) |
| Planet Type | T0 (Barren), T1 (Hostile), T2 (Cold), T3 (Desert), T4 (Tundra), T5 (Terrestrial), T6 (Gaia) |
| Terraforming Stages | 1. Melt Ice (if present) 2. Introduce Algae 3. Introduce Plants 4. Introduce Animals |
| Required Resources | Spice (for purchasing Terraforming Tool and resources) |
| Time Required | Several in-game years per stage |
| Effect on Planet | Increases planet's tier, making it more habitable and valuable |
| Max Terraforming Level | T6 (Gaia) - the most habitable and lush planet type |
| Cost | Varies depending on planet type and stage, but generally expensive |
| Benefits | Increased spice production, happier empire, and access to new creature types |
| Limitations | Cannot terraform planets with native civilizations or certain hazards (e.g., radiation) |
| Gameplay Impact | Essential for expanding your empire and increasing your score in the Space Stage |
| Tools Required | Terraforming Tool, Spice Harvesters (for resource collection) |
| Difficulty | Moderate to High, depending on planet type and available resources |
| In-Game Tips | Prioritize terraforming planets with high spice yields and strategic locations |
| Achievements | "Terraformer" achievement for terraforming a planet to T6 (Gaia) |
What You'll Learn
- Prepare the Core: Stabilize planetary core, ensure magnetic field, and initiate geothermal activity for long-term habitability
- Atmosphere Creation: Introduce gases, balance oxygen, nitrogen, and CO2 for breathable air and weather
- Hydrosphere Development: Seed oceans, rivers, and lakes, establish water cycle for ecosystems
- Flora Introduction: Plant resilient species, create food chains, and oxygenate the atmosphere
- Fauna Integration: Introduce herbivores and predators, balance ecosystems for sustainable biodiversity

Prepare the Core: Stabilize planetary core, ensure magnetic field, and initiate geothermal activity for long-term habitability
A planet's core is its heartbeat, and in the context of terraforming in *Spore*, stabilizing this core is the first step toward creating a thriving, habitable world. The core’s stability directly influences the planet’s magnetic field, geothermal activity, and long-term viability for life. Without a robust core, atmospheric erosion, radiation exposure, and tectonic stagnation threaten to render the planet uninhabitable. Think of it as laying the foundation for a house—if it’s weak, everything built upon it will crumble.
Step 1: Assess Core Composition and Temperature
Begin by analyzing the planet’s core using *Spore*’s planetary tools. Ideal cores are rich in iron and nickel, with temperatures exceeding 4,000°C. If the core is too small or cool, inject heavy elements like uranium or thorium to increase density and heat. For example, adding 5–10% thorium by mass can raise core temperature by 500°C within 10,000 in-game years. Avoid overloading, as excessive heat can cause runaway tectonic activity, leading to frequent catastrophic eruptions.
Step 2: Induce Magnetic Field Generation
A stable magnetic field shields the planet from solar radiation and prevents atmospheric stripping. If the core lacks sufficient convection currents, introduce a rotating metallic asteroid into the mantle. This simulates a dynamo effect, generating a magnetic field within 5,000 years. Monitor field strength using the planet’s health indicators—aim for a Gauss value above 0.25, comparable to Earth’s protective shield. Weak fields require additional iron injections or increased core rotation speed.
Step 3: Activate Geothermal Systems
Geothermal activity drives plate tectonics, regulates climate, and supports subsurface ecosystems. To initiate this, create fissures in the crust by bombarding the planet with small, icy comets. The resulting fractures allow heat to escape, forming volcanoes and hot springs. Focus on regions with low elevation, as these areas are more susceptible to geothermal activation. Maintain a balance—too many fissures can destabilize the crust, while too few stifle tectonic movement.
Cautions and Trade-offs
While stabilizing the core is critical, it’s a delicate process. Overheating the core can trigger supervolcanoes, rendering the surface inhospitable for centuries. Conversely, insufficient heat leads to a stagnant lithosphere, halting nutrient cycling. Additionally, magnetic fields require continuous core activity; if the dynamo weakens, radiation levels spike, threatening surface life. Always prioritize gradual adjustments over drastic interventions.
A stabilized core is the silent guardian of a terraformed planet, ensuring magnetic protection, geothermal balance, and tectonic vitality. By carefully managing its composition, temperature, and activity, you lay the groundwork for a world capable of sustaining life for millennia. In *Spore*, as in reality, the core is not just a geological feature—it’s the pulse that keeps the planet alive.
Effective Methods to Clean Spores Off Shrooms: A Shroomery Guide
You may want to see also

Atmosphere Creation: Introduce gases, balance oxygen, nitrogen, and CO2 for breathable air and weather
Creating a breathable atmosphere is a delicate dance of chemistry and balance. In *Spore*, this process involves introducing specific gases in precise ratios to mimic Earth-like conditions. Start by injecting nitrogen, which should compose about 78% of the atmosphere, serving as a stable, inert gas that prevents combustion while providing structural integrity. Next, introduce oxygen at around 21%, ensuring it’s enough to support life but not so high as to increase fire risks. Finally, add carbon dioxide at 0.04% to facilitate plant growth and regulate temperature through the greenhouse effect. This initial mixture forms the foundation for a habitable environment.
Balancing these gases isn’t just about percentages—it’s about creating a dynamic system that supports both life and weather patterns. Too much oxygen can lead to wildfires, while insufficient CO2 stifles plant life, disrupting the food chain. Monitor the atmosphere’s evolution, adjusting gas levels as the planet’s biosphere develops. For instance, as plants proliferate, they’ll naturally reduce CO2 levels while increasing oxygen, so periodic CO2 injections may be necessary to maintain equilibrium. Weather systems, such as rain and wind, will emerge as the atmosphere stabilizes, further shaping the planet’s ecology.
A practical tip for *Spore* players: use the game’s tools to simulate atmospheric changes over time. Start with a high CO2 concentration (e.g., 10%) to accelerate plant growth, then gradually reduce it as vegetation takes hold. Simultaneously, increase oxygen levels in tandem with plant proliferation, ensuring a smooth transition to a breathable atmosphere. Keep an eye on the planet’s temperature, as CO2 levels directly influence global warming—too much can lead to runaway greenhouse effects, while too little may cause freezing temperatures.
Comparing this process to real-world terraforming concepts highlights both similarities and limitations. On Mars, for example, scientists propose releasing CO2 trapped in ice to thicken the atmosphere, a strategy mirrored in *Spore*’s early CO2-heavy approach. However, *Spore* simplifies the complexities of gas interactions and planetary physics, allowing players to focus on creative experimentation. This makes it an ideal sandbox for understanding the principles of atmosphere creation without getting bogged down in real-world constraints.
In conclusion, mastering atmosphere creation in *Spore* requires a blend of precision and adaptability. By carefully introducing and balancing nitrogen, oxygen, and CO2, players can craft a world that not only supports life but also fosters diverse weather systems and ecosystems. Experimentation is key—tweak gas levels, observe the outcomes, and refine your approach until the planet thrives. This hands-on experience not only enhances gameplay but also deepens appreciation for the intricate science of terraforming.
Easy Step-by-Step Guide to Installing Spor on Your Device
You may want to see also

Hydrosphere Development: Seed oceans, rivers, and lakes, establish water cycle for ecosystems
Water is the lifeblood of any terraformed planet in Spore, and hydrosphere development is a delicate dance between seeding and sustainability. Begin by strategically placing oceans, rivers, and lakes across the planet's surface, ensuring a balanced distribution to prevent arid deserts or flooded continents. Use the terraforming tools to carve riverbeds and basins, allowing water to flow naturally and create diverse aquatic habitats. The key is to mimic Earth's hydrological patterns, where water bodies interconnect to form a cohesive network.
Once the physical framework is in place, focus on establishing a functional water cycle. This involves adjusting atmospheric conditions to encourage evaporation, condensation, and precipitation. Increase humidity levels to promote cloud formation, and introduce temperature gradients to drive weather patterns. For instance, warmer equatorial regions will foster evaporation, while cooler polar areas will facilitate condensation and rainfall. Monitor these dynamics closely, as an imbalance can lead to extreme weather events or stagnant water systems.
Seeding oceans with microbial life is the next critical step. Introduce phytoplankton and algae to kickstart the aquatic food chain, ensuring these organisms can thrive in the planet's unique conditions. Use the game's ecosystem editor to customize their resilience to temperature, salinity, and nutrient levels. Over time, these microorganisms will oxygenate the water, paving the way for more complex marine life. Be patient—this process can take several in-game years, but it’s essential for long-term ecological stability.
Rivers and lakes require a different approach. Populate these freshwater systems with species adapted to their specific environments. For example, lakes in volcanic regions may need heat-resistant organisms, while rivers in nutrient-rich areas can support diverse fish populations. Use the game’s tools to adjust water pH, mineral content, and flow rate to create optimal habitats. Remember, interconnected water bodies will allow species to migrate, fostering biodiversity and resilience.
Finally, maintain the water cycle by periodically adjusting planetary conditions. If evaporation rates drop, increase solar radiation or lower atmospheric pressure. If rainfall becomes erratic, introduce mountain ranges to act as natural barriers and condensation points. The goal is to create a self-sustaining system where water continuously cycles through the environment, supporting ecosystems without constant intervention. With careful planning and monitoring, your terraformed planet’s hydrosphere will become a thriving, dynamic component of its biosphere.
Are All Anaerobic Bacteria Spore-Forming? Unraveling the Microbial Mystery
You may want to see also

Flora Introduction: Plant resilient species, create food chains, and oxygenate the atmosphere
In the early stages of terraforming a planet in *Spore*, introducing flora is a critical step that serves as the foundation for all future life. Begin by selecting resilient plant species capable of surviving harsh conditions—think extremophiles like lichens or mosses that thrive in low oxygen and nutrient-poor soils. These pioneer species act as the first line of defense, stabilizing soil, preventing erosion, and beginning the slow process of atmospheric transformation. Their hardiness ensures they can endure until more complex ecosystems take root.
Once established, the next step is to create food chains that sustain both the flora and future fauna. Start with primary producers like algae or grasses, which convert sunlight into energy and serve as the base of the food web. Introduce herbivores that feed on these plants, followed by predators to maintain balance. For example, planting fast-growing ferns can support small grazing creatures, which in turn become prey for larger carnivores. This layered approach ensures energy flows efficiently through the ecosystem, fostering stability and growth.
Oxygenation is a dual-purpose process—it not only makes the planet habitable for complex life but also accelerates plant growth. Photosynthetic organisms like cyanobacteria or phytoplankton are ideal for this phase, as they release oxygen as a byproduct of their metabolic processes. To maximize their impact, distribute them across diverse environments, from shallow water bodies to rocky outcrops. Monitor atmospheric oxygen levels, aiming for a concentration of at least 20% to support larger, more oxygen-dependent species.
A cautionary note: avoid introducing invasive species that could outcompete native flora and disrupt the delicate balance of the emerging ecosystem. Instead, opt for species with complementary roles, such as nitrogen-fixing plants like legumes, which enrich the soil and support neighboring vegetation. Regularly assess the planet’s biodiversity, ensuring no single species dominates and that resources remain evenly distributed.
In conclusion, the introduction of flora in *Spore* is a strategic, multi-stage process that requires careful planning and execution. By starting with resilient species, building food chains, and prioritizing oxygenation, you lay the groundwork for a thriving, self-sustaining ecosystem. Each step builds upon the last, transforming a barren world into a lush, habitable environment ready for the next phase of evolution.
Does Bleach Kill Mold Spores? Uncovering the Truth Behind the Myth
You may want to see also

Fauna Integration: Introduce herbivores and predators, balance ecosystems for sustainable biodiversity
In the intricate dance of terraforming a planet in *Spore*, introducing fauna is not just about populating the landscape—it’s about crafting a living, breathing ecosystem. Begin by introducing herbivores first, as they form the base of the food chain. Opt for species with low resource consumption and high adaptability, such as grazers or browsers, to ensure they thrive without depleting vegetation too quickly. For instance, a small, rabbit-like creature with a diet of grasses and shrubs can sustain itself while allowing plant life to regenerate. This foundational step prevents ecological collapse and sets the stage for more complex interactions.
Once herbivores are established, carefully introduce predators to maintain balance. Start with mid-level predators that target the herbivore population without decimating it. A wolf-like creature, for example, can regulate herbivore numbers while avoiding overhunting if its population is kept in check by resource availability. Avoid apex predators initially, as they can destabilize the ecosystem before it matures. Monitor predator-prey ratios closely; a healthy balance is typically 1 predator for every 10-15 herbivores, depending on the species’ efficiency and resource consumption.
Sustainable biodiversity requires more than just balancing numbers—it demands habitat diversity. Design biomes with varied terrain, water sources, and vegetation to support multiple species niches. For instance, a forest biome can host tree-dwelling herbivores and ground predators, while a grassland supports grazers and burrowing creatures. This spatial segregation reduces competition and allows species to coexist. Use *Spore*’s terrain tools to create natural barriers like rivers or mountains, which can prevent overgrazing and encourage species to specialize in their environments.
Finally, introduce keystone species to enhance ecosystem resilience. These are species that have a disproportionately large impact on their environment relative to their abundance. For example, a beaver-like creature can create wetlands, increasing water retention and supporting aquatic life. Similarly, pollinators like insect-like creatures can accelerate plant reproduction, boosting vegetation density. Monitor these species’ effects carefully, as their influence can cascade through the ecosystem. By integrating herbivores, predators, and keystone species thoughtfully, you’ll create a dynamic, self-sustaining world that thrives long after your terraforming efforts.
Unveiling the Mystery of Fossil Spores: Counting Ancient Spores
You may want to see also
Frequently asked questions
Yes, terraforming is a key feature in the *Space Stage* of Spore. Players can alter a planet's environment by adjusting its atmosphere, temperature, and vegetation to make it habitable for their species or other life forms.
To begin terraforming, you need to enter the *Space Stage* and select a planet. Use the *Terraforming Tool* from your spaceship’s interface to modify the planet’s attributes, such as temperature, humidity, and atmosphere, until it becomes habitable.
Terraforming requires Spice, the game's primary currency in the *Space Stage*. The amount of Spice needed depends on the planet's current state and the desired changes. Collecting Spice from spice geysers, trading, or conquering planets helps fund terraforming efforts.
The time to terraform a planet varies based on its initial conditions and the extent of changes needed. It can take several in-game years, and progress is gradual. Players can speed up the process by investing more Spice and continuously monitoring the planet’s attributes.